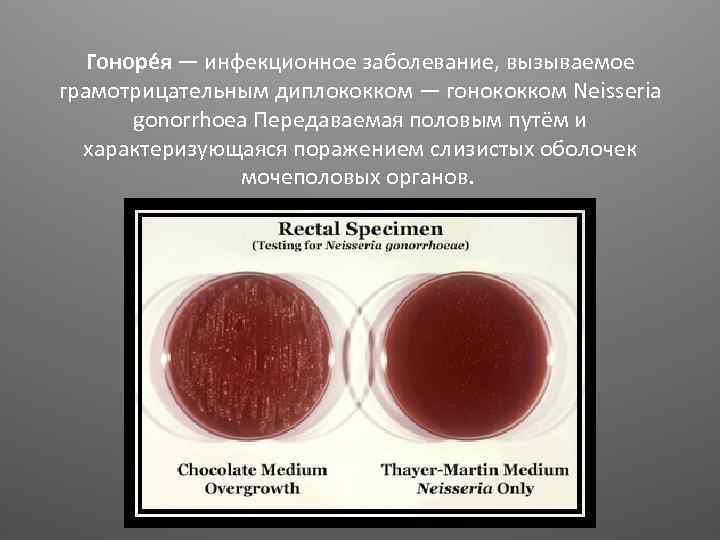
Гоноре я — инфекционное заболевание, вызываемое грамотрицательным диплококком — гонококком Neisseria gonorrhoea Передаваемая половым

Венерические заболевания.pptx
- Количество слайдов: 14

Венерические заболевания Презентацию поготовила Ращеня Дарья

Инфекцио нные заболева ния — группа заболеваний, вызываемых проникновением в организм патогенных (болезнетворных) микроорганизм ов, вирусов и прионов.

Си филис — хроническое системное венерическое инфекционное заболевание с поражением кожи, слизистых оболочек, внутренних органов, костей, нервной системы с последовательной сменой стадий болезни, вызываемое бактериями вида Treponema pallidum

Врождённый сифилис Сифилис может передаваться при беременности, от инфицированной матери ребёнку на 10 -16 неделях. Частые осложнения – самопроизвольные аборты и смерть плода ещё до родов. Врождённый сифилис по временным критериям и симптомам разделяют на ранний и поздний.

Симптомы венерических Кровянистые выделения из влагалища в период между месячными болезней Боль при мочеиспускании Симптомы у мужчин: Жжение и боль при мочеиспускании Выделения из полового члена Высыпания на половых органах Симптомы у женщин: Необычные выделения из влагалища Неприятный запах выделений из влагалища Жжение и зуд половых органов Боль при половом акте Боль внизу живота Высыпания на половых органах Симптомы, общие для мужчин и женщин: Боль в горле Боль и выделения из прямой кишки
Гоноре я — инфекционное заболевание, вызываемое грамотрицательным диплококком — гонококком Neisseria gonorrhoea Передаваемая половым путём и характеризующаяся поражением слизистых оболочек мочеполовых органов.

Заражение гонореей новорожденного ребенка Гонококки не могут проникнуть через неповреждённые плодные оболочки во время беременности, но преждевременный разрыв этих оболочек приводит к инфицированию околоплодных вод и плода. Заражение гонореей новорожденного может произойти прохождении его через родовые пути больной матери. Поражается при этом конъюнктива глаз, у девочек еще и половые органы. Слепота у новорождённых в половине случаев вызвана заражением гонореей.

Выявление заболевания Для диагностики используется осмотр пациента, выявление клинических симптомов

Для изучения лабораторных анализов образцов используются следующие методы: микроскопия культуральный метод выявление антигенов к возбудителю выявление ДНК возбудителя выявление антител в крови

Осложнения Не излеченные и длительно присутствовавшие в организме ИППП способны вызывать осложнения: мужское и женское бесплодие , простатит, воспалительные заболевания матки и придатков, эпидидимит, новообразования половых органов.

Профилактика Сексуально активным лицам, не имеющим единственного и здорового партнёра, необходимо помнить о правилах защищённого секса (презерватив) — хотя он и не обеспечивает 100 % надёжности для профилактики заражения. Всем сексуально-активным лицам рекомендуется ежегодное профилактическое обследование на сифилис, ВИЧ, гепатит B, даже при отсутствии симптомов.

Лечение Для лечения ИППП используются антибиотики, противовирусные или противопаразитарные средства, в зависимости от возбудителя инфекции.

Ответственность В России умышленное заражение другого лица венерической болезнью является преступлением , за это деяние установлена уголовная ответственность.

Задумайтесь !
Венерические заболевания.pptx